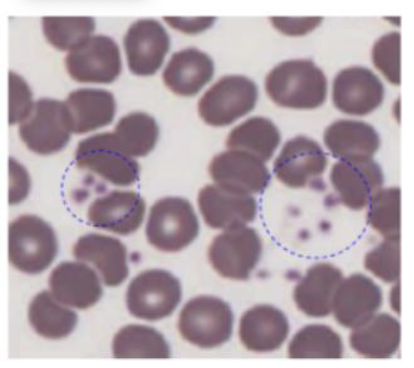
<p>What is circled?</p>

Lab Practical 2
1/62
There's no tags or description
Looks like no tags are added yet.
Name | Mastery | Learn | Test | Matching | Spaced | Call with Kai |
|---|
No analytics yet
Send a link to your students to track their progress
63 Terms

Identify


Identify + describe the nerve
CN I: Olfactory Nerve
sensory: smell


Identify + describe the nerve
CN II: Optic nerve
sensory: vision


Identify + describe the nerve
CN III: Oculomotor nerve
motor: movement of eye

Identify + describe the nerve
CN IV: trochlear
motor: movement of eye


Identify + describe the nerve
CN V: Trigeminal nerve
Sensory: forehead, eye, upper + lower jaw
motor: muscles of mastication

Identify + describe the nerve
CN VI: Abducens Nerve
motor: movement of they eye

Identify + describe the nerve
CN VII: Facial nerve
sensory: taste anterior 2/3 tongue
motor: muscles of facial expression, parasympathetic innervation of tear + salivary glands

Identify + describe the nerve
CN VIII: Vestibulocochlear nerve
Sensory: Equilibrium and hearing

Identify + describe the nerve
CN IX: Glossopharyngeal nerve
Sensory: sensory innervation of the pharynx, taste from posterior 1/3 tongue
Motor: pharynx muscles, parasympathetic innervation of salivary glands

Identify + describe the nerve
CN X: Vagus nerve
Sensory: sensory innervation of the larynx
motor: pharynx + larynx muscles, parasympathetic innervation of the thoracic + abdominal organs


Identify + describe the nerve
CN XI: Accessory nerve
motor: trapezius + sternocleodimastoid muscles


Identify + describe the nerve
CN XII: Hypoglossal nerve
motor: muscles of the tounge

Identify


Identify


Identify


Identify


Identify


Identify


Identify


Identify


Identify


Identify


Identify


Identify


Identify
Tympanic membrane

Identify




Identify


Identify


Identify

Hormones released by posterior lobe
Oxytocin
Antidiuretic hormone
Hormones released by anterior lobe
Thyroid stimulating hormone
prolactin
adrenocorticotropic hormone
growth hormones
follicle stimulating hormone
melanocyte stimulating hormone
luteinizing hormone

Identify
thyroid


Identify


Identify


Identify


Identify


Identify


Identify


Identify

What is circled?
Platelets

What cell is this
Neutrophils

What cell is this?
Eosinophils
Identify
Basophils

Identify


Identify


What is this? where is it found?
the wall between the left and right atria


What is circled?
Fossa ovalis
depression in the interatrial septum of the right atrium

Identify


Identify? what are its identification factors
Trabeculae Carneae
irregular muscular ridges on the internal walls of each ventricle

Identify? what is its identification factor
Papillary muscles
smaller muscular projection on the internal walls of ventricles that attach to valves of heart


Identify


Identify


Identify


Identify
Anterior pituitary

Identify
Posterior pituitary

What is circled in yellow
Acinar cells



Identify


What is circled in yellow
Colloid-filled Follicles

What is this?
Thyroid gland

What cells are these? what do they make up?
Principal (chief) cells
Parathyroid gland